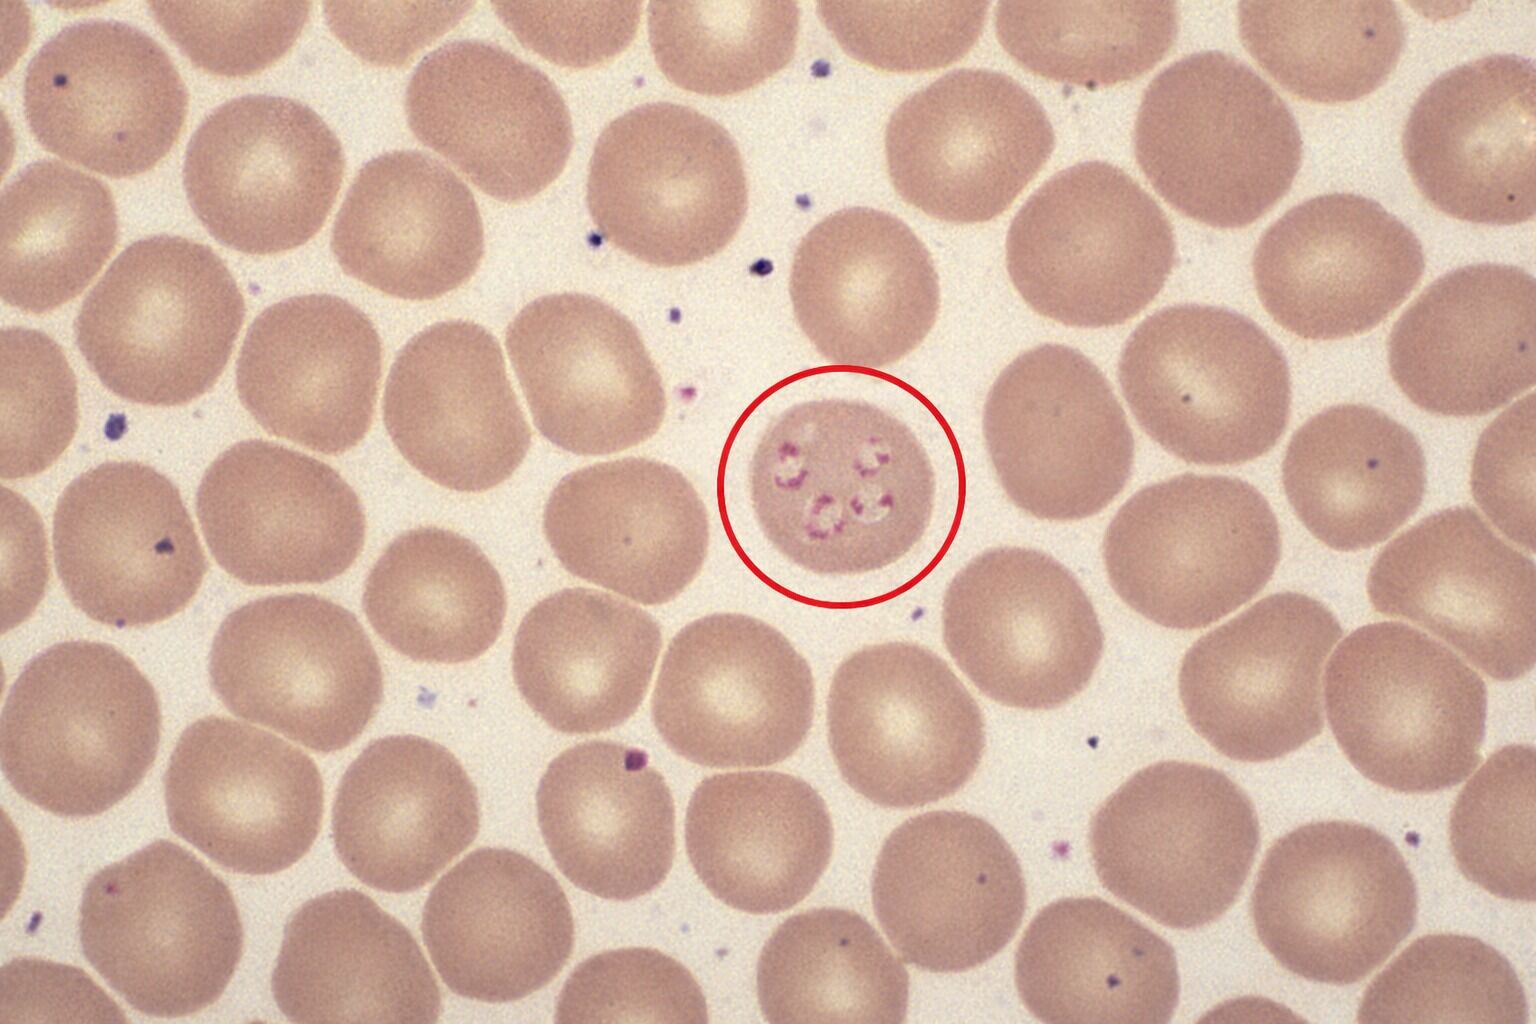
Imagem microscópica de células sanguíneas com destaque

- Blog
- Guia de Doenças
- Babesiose bovina: o que é, sintomas e como tratar
Babesiose bovina: o que é, sintomas e como tratar
Conteúdo
- O que é a babesiose bovina?
- Como os bovinos contraem a babesiose?
- 1. Transmissão por carrapatos (via biológica)
A saúde do rebanho é um dos pilares mais importantes da pecuária rentável, e poucas doenças testam esse pilar com tanta frequência quanto a babesiose bovina. Transmitida principalmente pelo carrapato Rhipicephalus (Boophilus) microplus, essa enfermidade parasitária está presente em praticamente todas as regiões tropicais do Brasil e responde por prejuízos que ultrapassam US$ 2 bilhões por ano no setor.
Neste conteúdo, você vai encontrar tudo o que precisa saber sobre a babesiose bovina: o que é a doença, como ela é transmitida, quais são os sintomas, como diagnosticar, tratar e, principalmente, como prevenir. Um guia para quem quer tomar decisões mais seguras e proteger a produtividade da propriedade. Continue a leitura e confira!O que é a babesiose bovina?
Na lista de doenças mais comuns em animais de grande porte, a babesiose bovina é uma doença sanguínea parasitária causada por protozoários do gênero Babesia, que afeta os bovinos e provoca redução na produção de leite e carne, além de grandes perdas econômicas. A transmissão ocorre principalmente por meio do carrapato Rhipicephalus (Boophilus) microplus, embora também possa acontecer por transfusões de sangue, mosquitos e até durante a gestação.Como os bovinos contraem a babesiose?
A babesiose bovina é transmitida principalmente pela picada de carrapatos infectados, que inoculam os protozoários Babesia spp. no sangue dos animais durante o repasto sanguíneo. Essa é a forma mais comum e eficiente de transmissão, conhecida como transmissão biológica. Além disso, existem outras vias secundárias de disseminação da doença que, embora menos frequentes, também merecem atenção no manejo sanitário do rebanho, sendo elas:1. Transmissão por carrapatos (via biológica)
Os carrapatos do gênero Rhipicephalus (Boophilus) microplus são os principais vetores da babesiose no Brasil. Os carrapatos adquirem a infecção ao se alimentarem do sangue de um animal doente e, posteriormente, transmitem a Babesia a bovinos saudáveis durante novos repastos. A transmissão pode ocorrer em diferentes estágios de desenvolvimento do carrapato (larva, ninfa e adulto), dependendo da espécie do protozoário. O parasita também pode ser transmitido de uma geração para outra dentro da população de carrapatos, por meio da transmissão transovariana, ou seja, as fêmeas infectadas passam o protozoário para sua prole, que infectará novos hospedeiros.2. Transmissão mecânica
A babesiose pode ser transmitida de forma acidental, quando há contaminação por instrumentos cirúrgicos ou de manejo (como agulhas, bisturis e materiais de vacinação). Esses objetos podem carregar sangue infectado e introduzir o protozoário em animais saudáveis.3. Transfusão de sangue
Animais que recebem transfusões de sangue de bovinos infectados podem contrair a doença. Por isso, esse procedimento deve ser feito com extrema cautela e sempre sob orientação de um médico, com controle rigoroso das amostras.4. Transmissão congênita
A Babesia spp. pode ser transmitida da mãe para o bezerro durante a gestação, caracterizando a transmissão congênita. Embora seja menos comum, pode levar ao nascimento de bezerros debilitados ou anêmicos, exigindo atenção redobrada nas propriedades com histórico da doença.5. Insetos hematófagos
Apesar de menos significativos que os carrapatos, outros insetos que se alimentam de sangue, como moscas e mutucas, podem atuar como vetores mecânicos ocasionais, transmitindo o agente de um animal infectado para outro. Por isso, o controle eficiente do carrapato dentro da propriedade rural continua sendo a principal estratégia de prevenção contra a babesiose. Boas práticas de manejo sanitário, como a higienização dos instrumentos de monitoramento reprodutivo, são fundamentais para reduzir os riscos de transmissão e manter o rebanho saudável e produtivo.
Sintomas da babesiose bovina: como identificar no rebanho
A babesiose bovina é uma doença que pode comprometer seriamente a saúde dos animais e a rentabilidade da propriedade rural. Reconhecer precocemente os sintomas é essencial para um tratamento eficaz e para evitar perdas econômicas significativas.Sintomas visíveis e comportamentais
- Febre alta: um dos primeiros sinais da infecção;
- Anemia e icterícia: mucosas (boca, olhos) pálidas ou amareladas, devido à destruição dos glóbulos vermelhos;
- Urina escura (hemoglobinúria): indicativo da intensa quebra de hemácias;
- Fraqueza e apatia: o animal se isola, mantém a cabeça baixa e as orelhas caídas;
- Perda de apetite: redução ou ausência de consumo de alimentos (anorexia);
- Pelos arrepiados e sem brilho: indicam queda no bem-estar e na nutrição;
- Prostração: o animal pode permanecer deitado por longos períodos e ter dificuldade para se levantar;
- Diminuição na produção: redução no ganho de peso e na produção de leite.
Sintomas graves
- Respiração acelerada e batimentos cardíacos elevados: consequência da baixa oxigenação no sangue;
- Alterações neurológicas: em infecções mais severas, podem surgir ranger de dentes, descoordenação motora, andar cambaleante, movimentos de pedalagem e agressividade, causados pelo bloqueio de capilares cerebrais pela Babesia bovis.
O que fazer ao identificar os sintomas?
- Procure um médico-veterinário: a confirmação diagnóstica deve ser feita por um profissional, por meio de exames clínicos e laboratoriais, como o esfregaço sanguíneo e análises complementares;
- Monitore o rebanho: observe atentamente mudanças de comportamento ou sinais clínicos em outros animais, para agir rapidamente e evitar a disseminação da doença;
- Controle o carrapato: a prevenção continua sendo a forma mais eficaz de reduzir os casos de babesiose, por meio de um manejo integrado de ectoparasitas;
Como diagnosticar a babesiose bovina?
O diagnóstico da babesiose bovina pode ser realizado a partir da avaliação clínica dos animais e de exames laboratoriais específicos. A detecção precoce é essencial para garantir um tratamento eficaz e evitar a disseminação da doença no rebanho.Avaliação clínica inicial
A observação atenta do rebanho é o primeiro passo:- Sinais clínicos: febre, anemia, mucosas pálidas ou amareladas, fraqueza, apatia e icterícia;
- Comportamento: tristeza, isolamento, pelo arrepiado, focinho seco e respiração acelerada;
- Temperatura corporal: animais com temperatura acima de 39,3 °C devem ser avaliados mais profundamente;
- Hemograma: pode indicar anemia (queda dos glóbulos vermelhos), além de redução de plaquetas e leucócitos, sugerindo infecção ativa.
Esfregaço sanguíneo
Método mais comum e rápido. O veterinário coleta uma amostra de sangue e examina ao microscópio, buscando parasitas dentro das hemácias. É especialmente útil durante a fase aguda da doença, quando há maior concentração do protozoário no sangue.Testes sorológicos
Detectam anticorpos contra a Babesia no soro dos animais. São importantes em casos de infecção crônica ou de baixa parasitemia, e podem auxiliar no monitoramento de surtos e controle sanitário dentro da propriedade.Reação em Cadeia da Polimerase (PCR)
Técnica molecular de alta sensibilidade. Permite:- Confirmar infecções com baixa carga parasitária;
- Diferenciar a Babesia de outros parasitas semelhantes;
- Identificar a espécie exata (Babesia bovis ou Babesia bigemina).
Importância do diagnóstico precoce da babesiose bovina
Um diagnóstico rápido e preciso é fundamental para:- Aumentar as chances de recuperação dos animais;
- Garantir um tratamento eficaz e direcionado;
- Isolar e monitorar os animais infectados, evitando novos casos;
- Reduzir perdas produtivas e econômicas na fazenda.
Como tratar a babesiose bovina?
A identificação precoce e o início rápido do tratamento são fundamentais para garantir a recuperação dos animais acometidos pela babesiose bovina. O tratamento deve sempre ser conduzido por um médico-veterinário, que definirá o protocolo mais adequado de acordo com a gravidade do caso. O principal objetivo é eliminar o parasita, controlar a inflamação e corrigir a anemia causada pela destruição das hemácias. Os métodos terapêuticos mais utilizados incluem:- Antiparasitários específicos: atuam diretamente contra os protozoários Babesia bovis e Babesia bigemina;
- Antibióticos de suporte: usados para prevenir ou tratar infecções secundárias;
- Vitaminas e minerais: especialmente o complexo B e o ferro, que auxiliam na recuperação do quadro anêmico;
- Terapia de hidratação: soros e reposição de eletrólitos ajudam a restabelecer o equilíbrio do organismo;
- Transfusão de sangue: indicada em casos graves de anemia severa, quando há risco de vida para o animal.
Como prevenir a doença do carrapato em bois?
A prevenção da babesiose bovina é fundamental para manter a saúde do rebanho e evitar prejuízos econômicos. As principais estratégias envolvem o controle efetivo de carrapatos, a vacinação e o manejo adequado dos animais, visando fortalecer a imunidade e reduzir os riscos de infecção.Controle de carrapatos
O carrapato Rhipicephalus (Boophilus) microplus é o principal vetor da doença, portanto, o seu controle é a base da prevenção:- Uso de carrapaticidas: realize aplicações periódicas, com intervalos de 4 a 6 semanas em áreas com alta infestação;
- Rotação de pastagens: alternar piquetes ajuda a interromper o ciclo de vida do carrapato, diminuindo sua população;
- Controle biológico: utilize agentes naturais que reduzam a presença de carrapatos sem prejudicar o meio ambiente;
- Manejo de microclima: evite o acúmulo de umidade em áreas de pasto, pois isso favorece o desenvolvimento de larvas e ninfas.
Vacinação
A vacinação é uma medida preventiva eficaz, principalmente em regiões endêmicas:- Bezerros: a vacinação precoce permite que os animais desenvolvam imunidade natural, com menor risco de manifestações clínicas;
- Adultos: animais adultos também podem ser vacinados, especialmente se estiverem expostos a áreas de risco, mas é importante considerar que as reações clínicas podem ser mais severas nessa faixa etária.
Outras medidas preventivas
- Evite o estresse: o estresse reduz a imunidade, aumentando a suscetibilidade à doença;
- Manejo de bezerros: permita o contato controlado com carrapatos em condições seguras, isso ajuda a desenvolver imunidade natural sem comprometer a saúde do animal;
- Quimioprofilaxia: em situações específicas, o uso estratégico de medicamentos, como o dipropionato de imidocarb, pode prevenir o aparecimento dos sintomas sob orientação veterinária.
Quais são os impactos econômicos da babesiose no rebanho?
A babesiose bovina, conhecida como parte do complexo da Tristeza Parasitária Bovina (TPB), representa uma das doenças que mais causam prejuízos à pecuária nacional. No Brasil, estima-se que as perdas ultrapassem US$ 2 bilhões por ano, considerando mortalidade, queda de produtividade e custos com controle e tratamento.Principais prejuízos econômicos
Os impactos da babesiose vão muito além do animal doente. Quando um surto se instala no rebanho, os reflexos aparecem na produção, na reprodução, no caixa da propriedade, e alguns deles persistem mesmo depois que os animais se recuperam. Entenda os principais:Mortalidade de animais
A babesiose pode ser fatal, especialmente em raças taurinas e bezerros jovens, resultando em perdas diretas do rebanho e comprometendo o progresso genético.Queda na produtividade
- Produção de leite: há uma redução significativa na quantidade e na qualidade do leite produzido durante e após os surtos;
- Ganho de peso e produção de carne: animais doentes apresentam desempenho zootécnico reduzido, atrasando o abate e impactando o rendimento da carcaça.
Custos com tratamento e prevenção
Os gastos com antiparasitários, antibióticos, exames laboratoriais, além do controle de carrapatos e medidas profiláticas, representam uma despesa considerável para os produtores. Além disso, o tratamento requer tempo e mão de obra especializada, elevando o custo operacional.Impactos reprodutivos
A babesiose pode provocar abortos, redução temporária da fertilidade e atrasos no ciclo reprodutivo, comprometendo a taxa de prenhez e o intervalo entre partos.Danos indiretos
- Lesões cutâneas que facilitam a entrada de outros agentes infecciosos;
- Período de recuperação prolongado, exigindo manejos mais intensivos;
- Redução do valor comercial dos animais afetados.
Controle como estratégia econômica
A babesiose bovina é um fator limitante para a produtividade da pecuária, e ignorá-la tem um custo alto. Seu controle exige vigilância sanitária constante, programas eficazes de combate ao carrapato e planejamento preventivo com o apoio técnico de um veterinário. Somente com um manejo integrado é possível minimizar as perdas financeiras e garantir a sustentabilidade do rebanho. E, quanto antes esse controle começa, menores são os prejuízos e maiores os resultados. Quer saber como produtores que adotaram o controle parasitário eficiente transformaram a produtividade das suas propriedades? Confira os casos de sucesso no blog do Pecuária Forte.
Dener Dias
Dener Dias é jornalista, apresentador de TV, roteirista, escritor, produtor, cantor, músico e compositor. Graduado em Comunicação Social/Jornalismo pela UFMS, gosta de escrever, principalmente sobre o Pantanal, pecuária e suas peculiaridades. É autor do livro-reportagem Poeira Branca, no qual narra sua aventura real como peão e repórter em...
Ler mais
